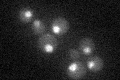
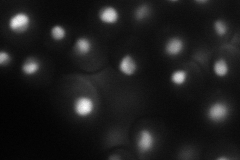
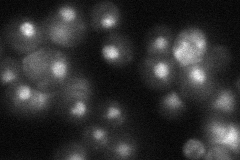
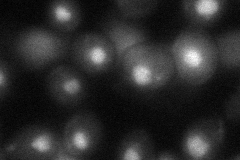

View description
Protein that interacts with exonuclease Rat1p and Rai1p and plays a role in transcription termination by RNA polymerase II, has an RPR domain (carboxy-terminal domain interacting domain); also involved in regulation of Ty1 transposition
Localization:
Intensity:
Fold change:
Significance:
-
C’ GFP library in SD
nucleus27.13 -
N' NOP1pr-GFP in SD
nucleus,nucleolus75.5184 -
N' TEF2pr-mCherry in SD

nucleus,nucleolus17.0414 -
N' NATIVEpr-GFP in SD
nucleus33.6292 -
N' TEF2pr-VC and Cyto-VN in SD
nucleus39.8833 -
C’ GFP library in SD+DTT

nucleus26.780.98No -
C’ GFP library in SD+H2O2

nucleus29.181.07No -
C’ GFP library in Starvation Media

nucleus32.731.2No -
C’ GFP library on the background of Pup2-DaMP

nucleus -
C’ GFP library on the background of CCT mutant

nucleus28.30281.04275No
